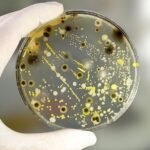

Рафаель Гроссі відомий як генеральний директор МАГАТЕ, який відіграє важливу роль у збереженні стабільності та безпеки у світі. Його діяльність охоплює контроль за використанням ядерних технологій, забезпеченням безпеки атомних об’єктів та підтримкою країн у мирному використанні атомної енергії.
Біографія Рафаеля Гроссі
Рафаель Гроссі народився 1961 року в Аргентині. Він отримав якісну освіту в галузі міжнародних відносин та розпочав свою дипломатичну кар’єру, зосередившись на питаннях ядерної енергетики та нерозповсюдження зброї. Його професійний шлях був пов’язаний з роботою у міністерстві закордонних справ Аргентини, а пізніше – у міжнародних організаціях.
Кар’єра та дипломатична діяльність
Завдяки своїм знанням і досвіду Рафаель Гроссі швидко здобув авторитет серед світових дипломатів. Він представляв Аргентину в різних міжнародних інституціях і був залучений до переговорів щодо безпеки. Його внесок у роботу МАГАТЕ розпочався задовго до того, як він очолив організацію.
Рафаель Гроссі як керівник МАГАТЕ

У 2019 році Рафаель Гроссіі був обраний генеральним директором МАГАТЕ. Це рішення стало визначальним, адже саме на нього поклали завдання посилити глобальний контроль за ядерними технологіями. Під його керівництвом агентство приділяє особливу увагу ядерній безпеці в умовах зростаючих політичних і військових ризиків у світі.
Значення діяльності Рафаеля Гроссі для України
Варто окремо відзначити його увагу до ситуації в Україні. Після початку війни він неодноразово відвідував нашу державу та особисто займався питаннями безпеки Запорізької атомної електростанції. Завдяки його зусиллям світова спільнота отримує достовірну інформацію про стан об’єктів, що знижує ризики глобальних катастроф.
Міжнародне визнання
Рафаель Гроссіі користується великою повагою серед політиків і науковців. Його часто запрошують на міжнародні конференції, де він представляє бачення МАГАТЕ щодо майбутнього ядерної енергетики. Водночас він виступає за баланс між мирним використанням атома та жорстким контролем за технологіями, що можуть становити загрозу.
Виклики та перспективи

Перед ним стоїть багато викликів. По-перше, це необхідність контролювати ситуацію у кризових регіонах. По-друге, потрібно зберегти довіру держав до МАГАТЕ. І нарешті, він має забезпечити розвиток ядерної енергетики як екологічно чистого джерела енергії. Рафаель Гроссі вважає, що лише спільні дії країн можуть гарантувати безпеку у майбутньому.
Висновок
Отже, Рафаель Гроссі – це не просто дипломат. Це людина, яка уособлює ідею глобальної співпраці задля безпечного майбутнього. Його діяльність у МАГАТЕ доводить, що роль однієї особистості може впливати на стабільність усього світу.
Читати далі: Брижит Макрон – унікальна історія життя та вплив на сучасну Францію
Часті запитання про Рафаеля Гроссі
Рафаель Гроссі – генеральний директор МАГАТЕ, дипломат з Аргентини, який спеціалізується на ядерній безпеці.
Він був обраний генеральним директором у 2019 році.
Він активно займається питаннями безпеки Запорізької АЕС і підтримує Україну в міжнародних організаціях.
Його робота допомагає контролювати використання ядерних технологій та запобігати глобальним катастрофам.
Це забезпечення ядерної безпеки у кризових регіонах, розвиток чистої енергетики та підтримка довіри до МАГАТЕ.